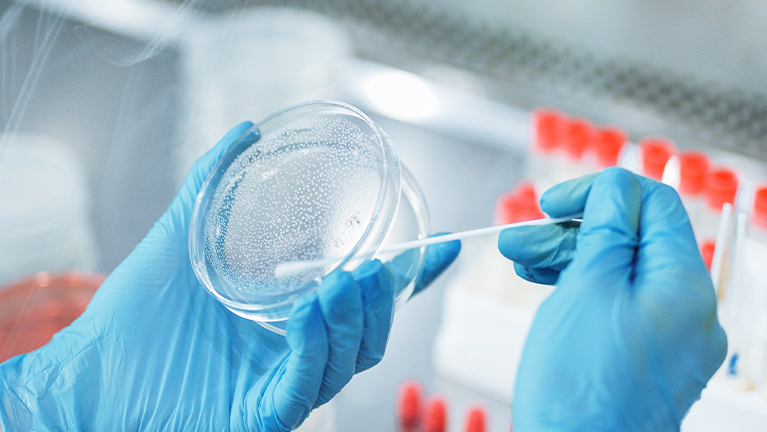

With many years of technical experience in the field of composition analysis, NOA is able to quickly determine the various components of target samples in the fields of unknown substance analysis, polymer materials, fine chemicals, medical devices, chemicals, etc., to identify samples qualitatively and quantitatively, to help companies control product quality, timely find and solve problems in the production process, to understand and improve product performance, to achieve further Product innovation.

Tel:+86-400 821 5138
Fax:+86-21 3327 5843
Email:noa@noagroup.com